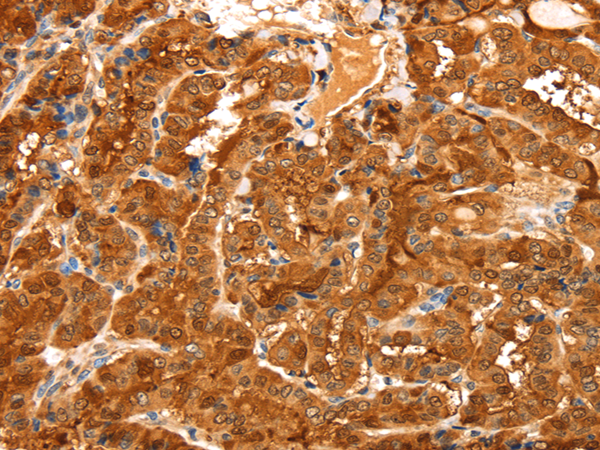
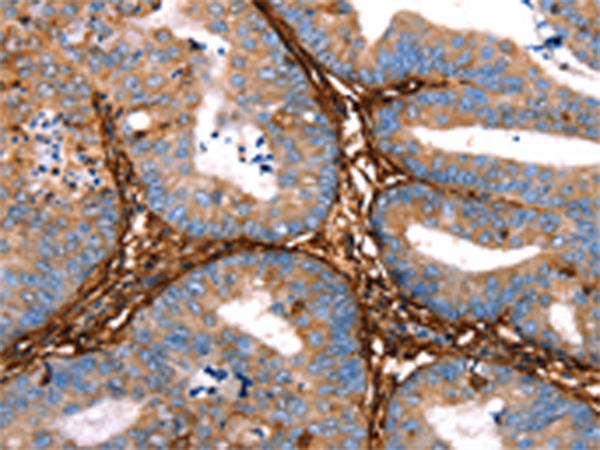
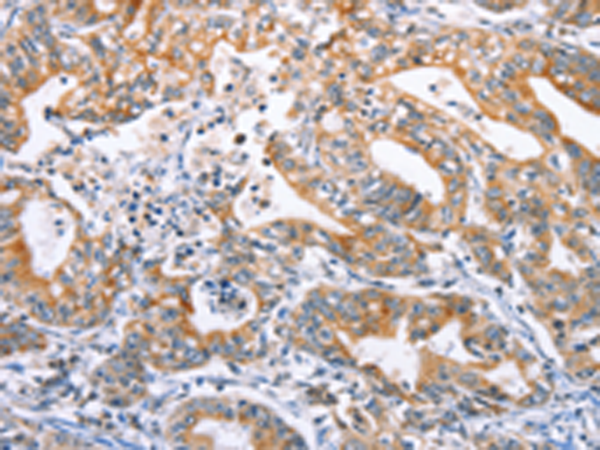

-
分类: 科研抗体货号: P07289别名: MRG, BLBP, FABPB, B-FABP应用: WB,IHC反应种属: Human, Mouse, Rat
-
分类: 科研抗体货号: P07293别名: CEK; FLG; HH2; OGD; ECCL; FLT2; KAL2; BFGFR; CD331; FGFBR; FLT-2; HBGFR; N-SAM; FGFR-1; HRTFDS; bFGF-R-1应用: IHC反应种属: Human, Mouse, Rat
-
分类: 科研抗体货号: P07288别名: aP2; ALBP; AFABP; A-FABP; HEL-S-104应用: WB,IHC反应种属: Human, Mouse, Rat
-
分类: 科研抗体货号: P07310别名: HL14应用: WB,IHC反应种属: Human, Mouse
-
分类: 科研抗体货号: P07287别名: DFNB24应用: WB,IHC反应种属: Human, Mouse
-
分类: 科研抗体货号: P07308别名: L31; GAL3; MAC2; CBP35; GALBP; GALIG; LGALS2应用: WB,IHC反应种属: Human
-
分类: 科研抗体货号: P07286别名: ET3; ET-3; WS4B; HSCR4; PPET3应用: WB,IHC反应种属: Human, Mouse
-
分类: 科研抗体货号: P07307别名: GBP, GAL1应用: WB,IHC反应种属: Human, Mouse, Rat
-
分类: 科研抗体货号: P07285别名: MKP5; MKP-5应用: IHC反应种属: Human, Mouse
-
分类: 科研抗体货号: P07306别名: GB5应用: WB,IHC反应种属: Human, Mouse, Rat

鄂公网安备42018502007531号
鄂公网安备42018502007531号

